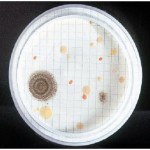
R
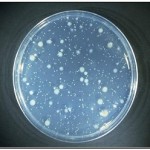
R

Agar Farmacopea para aerobios oligotrofos de las aguas ultrapurificadas
R2A oligotrofos Farmacopea es el medio de cultivo ideal para recuento de aerobios en aguas ultrapurificadas
R2 Medium Oligotrofic Agar (A.P.H.A.) (Pharmacopea medio S), recuento total en aguas potables, con máxima recuperación, al continuar las células en un medio tan oligotrófico como la muestra de agua. Recomendado para recuento en aguas cloradas y farmacéuticas.
|
Recuento total por filtración de membrana en un agua destilada: Gran recuperación y diversidad de flora mixta
|
|
Recuento total por siembra en masa. |
COMPOSICIÓN:
Extracto de levadura (0.50 g), Extracto de carne (0.50 g), Hidrolizado de caseína (0.50 g), Dextrosa-Glucosa (0.50 g), Almidón soluble (0.50 g), Di-K-Hidrógeno Fosfato (0.30 g), Sulfato de magnesio (0.024 g), Piruvato de sodio (0.30 g), Agar-Agar (15.00 g) (fórmula por litro.
pH final:
7.2 +/- 0.2
PREPARACIÓN:
Disolver 18 gramos de medio en 1 litro de agua bidestilada. Agitar, calentando hasta ebullición, hasta la total homogeneización. Autoclavar a 121ºC durante 15 minutos. MANTENER EL BOTE BIEN CERRADO EN LUGAR SECO, FRESCO Y OSCURO. AGITE EL BOTE ANTES DE USAR. DESHIDRATADO CÓDIGO: DMT215
CONTROL DE CALIDAD DEL MEDIO
Realizado en nuestro laboratorio; es prudente repetirlo en su laboratorio siempre que varíen las condiciones (más de 3 meses sin usar, tras desinfectar laboratorio, tras conservar a alta Tª, cuando adquiere aspectos extraños aunque no haya llegado la fecha de caducidad teórica de la etiqueta,…)
DESHIDRATADO: Polvo grueso, Beige.
PREPARADO: Estéril, Blanquecino.
CONTROL DE CRECIMIENTO CUANTITATIVO 72 h a 37°C aproximadamente (o bien 5 días a Tª ambiente 21-28°C aproximadamente):
Escherichia coli MKTA 25922, Correcto. Con respecto a PCA estandarizado*, recuento 132-161%
Enterococcus faecalis MKTA 29212, Correcto. Con respecto a PCA estandarizado*, recuento 166-177 %
Pseudomonas aeruginosa MKTA 9027, Correcto. Con respecto a PCA estandarizado*, recuento 85-143%
Staphylococcus aureus MKTA 6538P, Correcto. Con respecto a PCA estandarizado*, recuento 111-133%
Aeromonas hydrophila MKTA 49141, Correcto. Con respecto a PCA estandarizado*, recuento >100%.
* El que cumple con recuperación superior al 92-125% con respecto a cepas cuantitativas trazables a la cepa tipo. Incertidumbres detectadas entre todos los lotes a lo largo de un año (la mayoría de la incertidumbre se debe a la cepa y a la proporción de cepas acompañantes inoculadas, no al medio).
PRESENTACIÓN:
MEDIO DESHIDRATADO, FRASCOS PREPARADOS, PLAQUITAS HERMETICAS MF.
MODO DE EMPLEO E INTERPRETACIÓN DE RESULTADOS
Inocular 1 ml en profundidad o mejor 0,1 ml en superficie, o aún mejor una membrana en superficie por la que se hayan filtrado 1-100 ml de muestra. Duplicar la muestra. Incubar una placa 5-7 días a 22 ºC aproximadamente y la otra 3 días a 30-37 ºC aproximadamente. Contar todas las colonias, que serán muchas más que en medios normales como PCA, TSA, Nutrient Agar, Total Charcoal Agar, LPT Neutralizing Agar… ( Sanchís, 9/99, Interlaboratorio sobre la recuperción de medios nutritivos para recuento total en aguas, XVII Congreso S.E.M.). La flora termófila se asocia a procedencia humana. La mesófila al proceso de depuración. Este medio no es adecuado para recuento en alimentos, superficies o aire, sólo es mucho más sensible en aguas puras.
El usuario es el único responsable de la eliminación de los microorganismos según la legislación medioambiental vigente. Autoclavar antes de desechar a la basura.
Para cualquier consulta o aclaración sobre este producto u otros no dude en ponerse en contacto con nosotros en el teléfono (91) 897 46 16 o en el e-mail microkit@microkit.es.
https://www.microkit.es/fichas/R2-MEDIUM-OLIGOTROFIC-AGAR.pdf